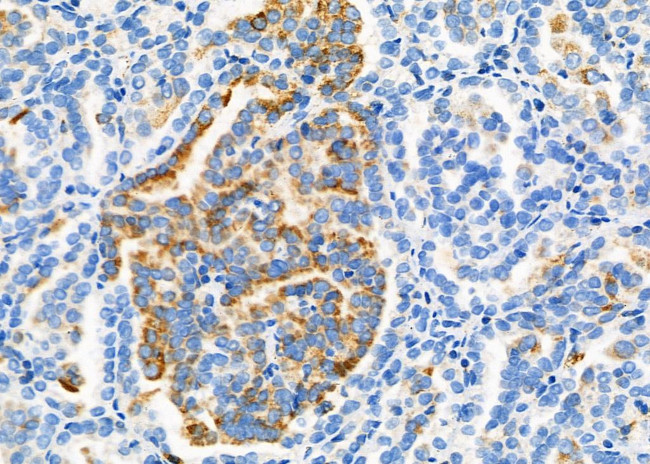
ROBO1 Antibody in Immunohistochemistry (Paraffin) (IHC (P))

Search
Invitrogen
ROBO1 Polyclonal Antibody
{{$productOrderCtrl.translations['antibody.pdp.commerceCard.promotion.promotions']}}
{{$productOrderCtrl.translations['antibody.pdp.commerceCard.promotion.viewpromo']}}
{{$productOrderCtrl.translations['antibody.pdp.commerceCard.promotion.promocode']}}: {{promo.promoCode}} {{promo.promoTitle}} {{promo.promoDescription}}. {{$productOrderCtrl.translations['antibody.pdp.commerceCard.promotion.learnmore']}}
图: 1 / 2
ROBO1 Antibody (PA5-115850) in IHC (P)


Please note: We are reviewing Western blot images included in the antibody testing data in our catalog, including those provided by third parties. Unless expressly labeled or annotated as “raw-unedited”, Western blot images included in the antibody testing data in our catalog may have been edited, optimized or otherwise adjusted for presentation.
产品信息
PA5-115850
种属反应
宿主/亚型
分类
类型
抗原
偶联物
形式
浓度
规格
纯化类型
保存液
内含物
保存条件
运输条件
RRID
产品详细信息
Antibody detects endogenous levels of total ROBO1.
靶标信息
Specialized cells at the midline, which separates the left and right halves of the CNS, have a number of roles in directing growth cone behavior. In the vertebrate spinal cord, the insect ventral nerve cord and in C. elegans, midline cells produce guidance cues such as nectins and slit, which act as attractants and repellents, respectively. These cells may act as gatekeepers to prevent axons from crossing the midline and to induce a switch in growth cone responsiveness to guidance cues beyond the gateway. One such gatekeeper, Robo, is an axon guidance receptor that defines a novel subfamily of Ig superfamily proteins that are conserved from fruit flies to mammals. Robo acts as a receptor for the repellent Slit and functions in a cell-autonomous fashion. Non-crossing axons express high levels of Robo, whereas crossing axons express low levels of Robo before reaching the midline and high levels after they cross. Robo1 and Robo2 are two human homologs of the Drosophila protein Roundabout. Robo1 is also homologous to the C. elegans gene sax3, whereas Robo2 is homologous to the zebrafish gene astray.
仅用于科研。不用于诊断过程。未经明确授权不得转售。
篇参考文献 (0)
生物信息学
蛋白别名: Deleted in U twenty twenty; FLJ21882; H-Robo-1; HGNC:10249; MGC131599; MGC133277; roundabout 1; Roundabout homolog 1
基因别名: AW494633; AW742721; DUTT1; Gm310; ROBO1
UniProt ID: (Rat) O55005, (Mouse) O89026
Entrez Gene ID: (Rat) 58946, (Mouse) 19876